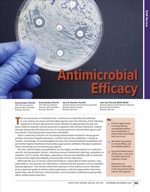
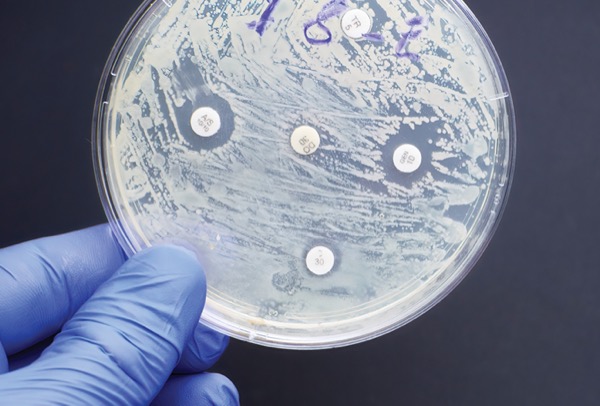

Rochester General Hospital
Rochester, New York
Rochester General Hospital
Rochester, New York
Rochester General Hospital
Rochester, New York
Rochester General Hospital
Rochester, New York
This annual review is intended to be a reference to describe the potential in vivo activity of various antimicrobial agents when the identity of the infecting organism is known. Because the early initiation of appropriate therapy has been noted to improve clinical outcomes in patients with serious infections, empiric therapy frequently demands the use of a broad-spectrum antimicrobial agent until the specific infecting bacteria have been identified.
Given continuing concerns of increasing antimicrobial resistance among gram-positive and gram-negative bacteria—and the lack of new antibiotics coming to market—knowledge of microbiological activity and clinical treatment guidelines will permit the highest likelihood of providing appropriate antibiotic therapy to patients while minimizing use of unnecessary agents.
Of note, antimicrobial susceptibilities can be highly variable based on institution-specific and geographic factors, including various institutional sites (eg, outpatient vs inpatient, ICU vs ward). Therefore, awareness of local susceptibility data is essential to ensure the highest probability of successful clinical outcomes.
Although the use of various dosing techniques, especially for beta-lactams, may potentiate in vivo activity, the information contained herein pertains only to standard dosing regimens. This review reflects the opinions of the authors and is intended to be a general guide to antimicrobial applications, with the appreciation that host factors (eg, site of infection, clinical picture, and comorbid conditions) could greatly affect antimicrobial selection.
Tables 1–3
| Antimicrobial Efficacy for Selected Pathogen: |
| Amoxicillin | ||
| Ampicillin | ||
| Cloxacillin/dicloxacillin | ||
| Nafcillin/oxacillin | ||
| Penicillin G | ||
| Penicillin V | ||
| Amoxicillin-clavulanate | ||
| Ampicillin-sulbactam | ||
| Piperacillin-tazobactam | ||
| Doripenem | ||
| Ertapenem | ||
| Meropenem | ||
| Imipenem-cilastatin | ||
| Imipenem-cilastatin-relebactam | ||
| Meropenem-vaborbactam | ||
| Aztreonam |
| Cefadroxil | |||
| Cefazolin | |||
| Cephalexin | |||
| Cefaclor | |||
| Cefotetan | |||
| Cefoxitin | |||
| Cefuroxime | |||
| Cefdinir | |||
| Cefotaxime | |||
| Cefpodoxime proxetil | |||
| Ceftazidime | |||
| Ceftriaxone | |||
| Cefepime | |||
| Ceftaroline | |||
| Ceftazidime-avibactam | |||
| Ceftolozane-tazobactam | |||
| Cefiderocol | |||
| Amikacin | ||
| Gentamicin | ||
| Plazomicinac | ||
| Streptomycin | ||
| Tobramycin | ||
| Azithromycin | ||
| Clarithromycin | ||
| Erythromycin | ||
| Fidaxomicin | ||
| Ciprofloxacin | ||
| Delafloxacin | ||
| Levofloxacin | ||
| Moxifloxacin | ||
| Tetracyclines (eg, doxycycline, minocycline)t | ||
| Eravacycline | ||
| Omadacycline | ||
| Tigecycline | ||
| Vancomycin | ||
| Dalbavancinz | ||
| Oritavancin | ||
| Telavancin | ||
| Linezolid | ||
| Tedizolid | ||
| Chloramphenicol | ||
| Clindamycin | ||
| Colistin/polymixin B | ||
| Daptomycins | ||
| Lefamulin | ||
| Metronidazole | ||
| Quinupristin-dalfopristin | ||
| Rifampin | ||
| Durlobactam-sulbactam | ||
| Telithromycin | ||
| Trimethoprim-sulfamethoxazole | ||
| Fosfomycin (oral formulation only) | ||
| Nitrofurantoin | ||
| Pivmecillinam |
Table 4. Multidrug Resistance | ||||||||||||
| Activity against beta-lactamases | Coverage against beta-lactam–resistant isolates | |||||||||||
|---|---|---|---|---|---|---|---|---|---|---|---|---|
| Drug | KPC | OXA-48 | Other OXA | NDM | VIM | IMP | AmpC | KPC (CRE) | MBL (CRE) | DTR-PsA | A. baumannii | S. maltophilia |
| Ceftolozane-tazobactam | 1 | |||||||||||
| Durlobactam-sulbactam | 1 | |||||||||||
| Meropenem-vaborbactam | 1 | 3 | 1 | |||||||||
| Imipenem-cilastatin-relebactam | 2 | 3 | 2 | 2 | ||||||||
| Ceftazidime-avibactam | 2 | 1 | 11 | 11 | 11 | 3 | 2 | 11 | 2 | 11 | ||
| Cefiderocol | 2 | 3 | 3 | 2 | 2 | 2 | 3 | 3 | 2 | 3 | 3 | 2 |
| 1 Must be used in synergy with aztreonam. Based on https://www.idsociety.org/practice-guideline/amr-guidance/#AmpC%CE%B2-Lactamase-ProducingEnterobacterales; https://pubmed.ncbi.nlm.nih.gov/34849997/ | ||||||||||||
Table 5. AmpC Inducers | ||
| AmpC resistance | ||
|---|---|---|
| Moderate/high-risk inducers | Recommended treatment | Avoid |
| Citrobacter freundii | Nitrofurantoin1 | Ceftazidime |
| Enterobacter cloacae complex | Carbapenem2 | Cefotaxime |
| Klebsiella aerogenes | Trimethoprim-sulfamethoxazole3,4 | Piperacillin-tazobactam |
| Hafnia alvei | Cefepime | Ceftriaxone3 |
| Yersinia enterocolitica | Aminoglycosides4 Fluoroquinolones5,6 Refer to Table 4 for broader last-line options | Ampicillin-sulbactam |
| MIC, minimum inhibitory concentration. 1 Preferred options for AmpC uncomplicated cystitis. 2 Preferred option when cefepime MIC =4 mcg/mL, assuming carbapenem susceptibility is demonstrated. 3 Reasonable for uncomplicated cystitis caused by these organisms when susceptibility is demonstrated. 4 Alternative option for AmpC uncomplicated cystitis, pyelonephritis, and complicated urinary tract infection. 5 Can be considered for the treatment of invasive infections caused by moderate- to high-risk AmpC inducers. 6 Alternative options for AmpC uncomplicated cystitis. | ||
Footnotes
a Resistance to penicillin, tetracycline, and ciprofloxacin may be as high as 16.2%, 25.3%, and 19.2%, respectively, according to a 2014 report; dual therapy with ceftriaxone plus azithromycin is the only recommended gonorrhea treatment.
b Use a combination, eg, doxycycline with gentamicin or rifampin or doxycycline with trimethoprim-sulfamethoxazole and chloramphenicol.
c Combination therapies with high eradication rates include omeprazole + clarithromycin + amoxicillin as well as bismuth subsalicylate + metronidazole + tetracycline. However, metronidazole resistance has risen significantly.
d Up to 50% of Haemophilus influenzae strains are capable of producing beta-lactamases.
e Citrobacter spp and Enterobacter spp may differ in susceptibility patterns. Consult individual test results for appropriate choice.
f Carbapenem-resistant enterobacterales (CRE) are increasing and are endemic in certain geographic regions. Viable treatment options are limited and should be based on susceptibilities. For serious CRE infections, ceftazidime-avibactam or meropenem-vaborbactam should be preferred. Due to poor clinical outcomes with monotherapy, combination therapy with an aminoglycoside, including plazomicin (see footnote ac), colistin/polymyxin B, or tigecycline, based on local susceptibility results, is encouraged.
g A significant number of strains are capable of producing extended-spectrum beta-lactamases (ESBL). Consider this possibility according to antibiogram, patient’s history, and local resistance patterns. In suspected or proven cases, use carbapenems or proper non–beta-lactam antibiotics based on susceptibility studies.
h Combination therapy is suggested, particularly during empiric treatment until susceptibility results are finalized.
i When parenteral penicillin is used to treat a non-CNS pneumococcal infection, 94.8% of isolates are susceptible, 3.1% are intermediate, and 2.1% are resistant. Approximately 10% and 24% of Streptococcus pneumoniae strains in the United States are resistant to clindamycin and macrolides, respectively.
j PRSP (penicillin-resistant S. pneumoniae) is defined as nonsusceptible to penicillin with an minimum inhibitory concentration >_8 mcg/mL for non-CNS infections (parenteral therapy), >_2 mcg/mL for non-CNS infections (oral therapy), and >_0.12 mcg/mL for CNS infections.
k Amoxicillin doses of 80-90 mg/kg/d may be effective against non-meningeal PRSP infections.
l For updates, see https://bit.ly/2JMRyQf.
m Membranous pharyngitis treated with antitoxin and IV erythromycin (antimicrobials used to decrease toxin production and bacterial spread).
n New classification: Bacteria are gram-variable.
o Aminoglycosides (gentamicin) may be synergistic with beta-lactams.
p Oral vancomycin is recommended as first-line therapy for initial episodes of Clostridioides difficile infection (CDI), regardless of the severity of presentation. Fidaxomicin was found to be noninferior to oral vancomycin in treating CDI and superior in preventing recurrences of non-NAP1/BI/027 strains; therefore, it is also a first-line option. Metronidazole is no longer recommended for first episodes of CDI unless vancomycin and fidaxomicin are contraindicated or unavailable.
q Stage of disease determines choice of treatment. Consult specific references.
r Fluoroquinolone resistance rates can vary greatly against P. aeruginosa, Acinetobacter spp, and the enterobacterales. Use as empiric therapy against these organisms should be based on local susceptibilities.
s Despite its potent in vitro activity against S. pneumoniae, daptomycin is not indicated for the treatment of pneumonia, due to extensive binding to pulmonary surfactant, which results in clinical failure.
t The specific tetracycline recommended varies. For methicillin-resistant Staphylococcus aureus, minocycline is most active among class. Consult specific references.
u These agents generally are recommended for urinary tract infections (UTIs) only. Use of the “1” to “3” scale refers to activity for treatment of UTIs.
v Vancomycin is considered first-line when IV therapy is required. Dalbavancin or oritavancin may be considered first-line treatment for acute bacterial skin and skin structure infections caused by CA-MRSA in EDs with adequate clinical pathways for follow-up. Ceftaroline, daptomycin, linezolid, tedizolid, telavancin, and tigecycline may be suitable alternatives in specified patients. Tetracyclines, clindamycin, trimethoprim-sulfamethoxazole, macrolides, tedizolid, and linezolid are viable alternatives when oral therapy can be used. In the face of erythromycin resistance, clindamycin should be considered only if the isolate is D-test–negative.
w Vancomycin is considered first-line when IV therapy is required. In recent years, vancomycin MICs have gradually increased for S. aureus and have included an increased occurrence of heteroresistance. Clinical reports have associated this loss of in vitro potency with vancomycin clinical failures in a number of patients. Alternative therapies such as ceftaroline, daptomycin, linezolid, telavancin, and tigecycline should be considered in the appropriate clinical setting. Consult specific references.
x Effective choice for meningeal infections if the ceftriaxone/cefotaxime MIC <0.5 mcg/mL.
y Dalbavancin is not active against vancomycin-resistant enterococci (VRE) exhibiting vanA resistance.
z Dalbavancin may be given as either a single dose of 1,500 mg or as 1,000 mg administered on day 1 followed by 500 mg on day 8 for patients with normal kidney function.
aa Higher doses of daptomycin (>8 mg/kg) have resulted in reduced mortality and may be associated with improved microbiological outcomes in the setting of VRE bacteremia.
ab The sulbactam component of ampicillin-sulbactam has in vitro activity against some Acinetobacter baumannii and has been used successfully to treat serious Acinetobacter infections when the organism was reported to be susceptible. High-dose recommendation.
ac Plazomicin is approved for the treatment of adults with complicated UTIs, including pyelonephritis due to certain enterobacterales. Due to limited clinical and safety data, it should be reserved for patients with limited or no alternative treatment options. In particular, plazomicin is active against CRE that produce most aminoglycoside-modifying enzymes that inactivate other aminoglycoside antibiotics. Data from patients with bloodstream infections due to CRE suggest it may play a role when combined with another antibiotic.
ad Enterobacter aerogenes now reclassified as Klebsiella aerogenes.
ae Inducible AmpC resistance genes may render this agent ineffective against this organism.
af In clinical trials, the use of cefiderocol among patients with Serratia infections was limited to those with ventilator-associated pneumonia only.
ag Agents used to treat this organism should be optimized to achieve therapeutic concentrations within the CNS.
ah This recommendation is based on preclinical studies alone, ie, in vitro studies and in vivo animal models.
ai Must be used in synergy with aztreonam.
Suggested Reading
- Abdelraouf K, Linder KE, Nailor MD, et al. Predicting and preventing antimicrobial resistance utilizing pharmacodynamics: part II gram-negative bacteria. Expert Opin Drug Metab Toxicol. 2017;19:1-10.
- Bassetti M, Giacobbe DR, Giamarellou H, et al. Management of KPC-producing Klebsiella pneumoniae infections. Clin Microbiol Infect. 2018;24(2):133-144.
- Brook I. Spectrum and treatment of anaerobic infections. J Infect Chemother. 2016;22(1):1-13.
- Datta R, Juthani-Mehta M. Nitrofurantoin vs fosfomycin: rendering a verdict in a trial of acute uncomplicated cystitis. JAMA. 2018;319(17):1771-1772.
- Ferrara AM. Potentially multidrug-resistant nonfermentative gram-negative pathogens causing nosocomial pneumonia. Int J Antimicrob Agents. 2006;27(3):183-195.
- Gordon KA, Biedenbach DJ, Jones RN. Comparison of Streptococcus pneumoniae and Haemophilus influenzae susceptibilities from community-acquired respiratory tract infections and hospitalized patients with pneumonia: five-year results for the SENTRY Antimicrobial Surveillance Program. Diagn Microbiol Infect Dis. 2003;46(4):285-289.
- Hackel M, Kazmierczak KM, Hoban DJ, et al. Assessment of the in vitro activity of ceftazidime-avibactam against multidrug-resistant Klebsiella spp. Collected in the INFORM Global Surveillance Study, 2012 to 2014. Antimicrob Agents Chemother. 2016;60(8):4677-4683.
- Hansen GT, Blondeau JM. Comparison of the minimum inhibitory, mutant prevention and minimum bactericidal concentrations of ciprofloxacin, levofloxacin and garenoxacin against enteric gram-negative urinary tract infection pathogens. J Chemother. 2005;17(5):484-492.
- Hawser SP, Bouchillon SK, Hoban DJ, et al. In vitro susceptibilities of aerobic and facultative anaerobic Gram-negative bacilli from patients with intra-abdominal infections worldwide from 2005-2007: results from the SMART study. Int J Antimicrob Agents..2009;34(6):585-588.
- Howard A, O’Donoghue M, Feeney A, et al. Acinetobacter baumannii: an emerging opportunistic pathogen. Virulence. 2012;3(3):243-250.
- Kuti JL, Florea NR, Nightingale CH, et al. Pharmacodynamics of meropenem and imipenem against Enterobacteriaceae, Acinetobacter baumannii, and Pseudomonas aeruginosa. Pharmacotherapy. 2004;24(1):8-15.
- Linder KE, Nicolau DP, Nailor MD. Epidemiology, treatment, and economics of patients presenting to the emergency department for skin and soft tissue infections. Hosp Pract (1995). 2017;45(1):9-15.
- Liu C, Bayer A, Cosgrove SE, et al. Clinical practice guidelines by the Infectious Diseases Society of America for the treatment of methicillin-resistant Staphylococcus aureus infections in adults and children. Clin Infect Dis. 2011;52:e18-e55.
- Miller WR, Murray BE, Rice LB, et al. Vancomycin-resistant enterococci: therapeutic challenges in the 21st century. Infect Dis Clin North Am. 2016;30(2):415-439.
- Morrill HJ, Morton JB, Caffrey AR, et al. Antimicrobial resistance of Escherichia coli urinary isolates in the Veterans Affairs health care system. Antimicrob Agents Chemother. 2017;61(5):e02236-16.
- Nordmann P, Cuzon G, Naas T. The real threat of Klebsiella pneumoniae carbapenemase producing bacteria. Lancet Infect Dis. 2009;9(4):228-236.
- Ofosu A. Clostridium difficile infection: a review of current and emerging therapies. Ann Gastroenterol. 2016;29(2):147-154.
- Petersen PJ, Bradford PA, Weiss WJ, et al. In vitro and in vivo activities of tigecycline (GAR-936), daptomycin, and comparative antimicrobial agents against glycopeptide-intermediate Staphylococcus aureus and other resistant gram-positive pathogens. Antimicrob Agents Chemother. 2002;46(4):2595-2601.
- Pitout JD, Laupland KB. Extended-spectrum beta-lactamase-producing Enterobacteriaceae: an emerging public-health concern. Lancet Infect Dis. 2008;8(3):159-166.
- Pollack CV Jr, Amin A, Ford WT Jr, et al. Acute bacterial skin and skin structure infections (ABSSSI): practice guidelines for management and care transitions in the emergency department and hospital. J Emerg Med. 2015;48(4):508-519.
- Rhomberg PR, Fritsche TR, Sader HS, et al. Comparative antimicrobial potency of meropenem tested against gram-negative bacilli: report from the MYSTIC surveillance program in the United States (2004). J Chemother. 2005;17(8):459-469.
- Sader HS, Farrell DJ, Flamm RK, et al. Antimicrobial susceptibility of gram-negative organisms isolated from patients hospitalised with pneumonia in US and European hospitals: results from the SENTRY Antimicrobial Surveillance Program, 2009-2012. Int J Antimicrob Agents. 2014;43(4):328-334.
- Sutherland CA, Nicolau DP. Potency of parenteral antimicrobials including ceftolozane/tazobactam against nosocomial respiratory tract pathogens: considerations for empiric and directed therapy. J Thorac Dis. 2017;9(1):214-221.
- Trampuz A, Zimmerli W. Antimicrobial agents in orthopaedic surgery: prophylaxis and treatment. Drugs. 2006;66(8):1089-1105.
- Unemo M, Shafer WM. Antimicrobial resistance in Neisseria gonorrhoeae in the 21st century: past, evolution, and future. Clin Microbiol Rev. 2014;27(3):587-613.
- Van Bambeke F, Michot JM, Van Eldere J, et al. Quinolones in 2005: an update. Clin Microbiol Infect. 2005;11(4):256-280. Erratum in: Clin Microbiol Infect. 2005;11(6):513.
- Yamaguchi T, Hashikita G, Takahashi S, et al. In vitro activity of beta-lactams, macrolides, telithromycin, and fluoroquinolones against clinical isolates of Streptococcus pneumoniae: correlation between drug resistance and genetic characteristics. J Infect Chemother. 2005;11(5):262-264.
- Zhanel GG, Chung P, Adam H, et al. Ceftolozane/tazobactam: a novel cephalosporin/beta-lactamase inhibitor combination with activity against multidrug-resistant gram-negative bacilli. Drugs. 2014;74(1):31-51.
Copyright © 2024 McMahon Publishing, 545 West 45th Street, New York, NY 10036. Printed in the USA. All rights reserved, including the right of reproduction, in whole or in part, in any form.
Download to read this article in PDF document:![]() Antimicrobial Efficacy
Antimicrobial Efficacy